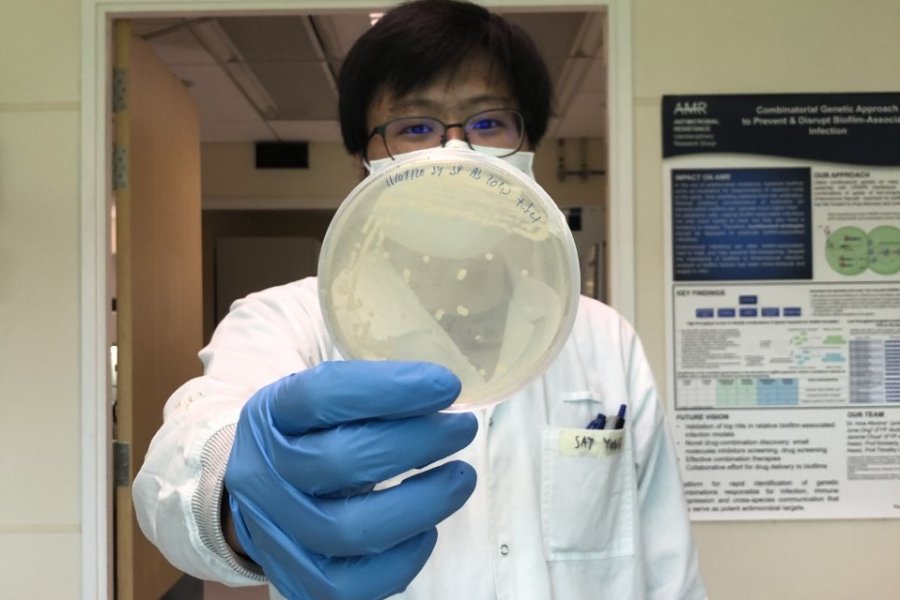

Researchers from the Singapore-MIT Alliance for Research and Technology (SMART), MIT’s research enterprise in Singapore, have discovered a new way to reverse antibiotic resistance in some bacteria using hydrogen sulfide (H2S). Growing antimicrobial resistance is a major threat for the world with a projected 10 million deaths each year by 2050 if no action is taken. The World Health Organization also warns that by 2030, drug-resistant diseases could force up to 24 million people into extreme poverty and cause catastrophic damage to the world economy. In most bacteria studied, the…


